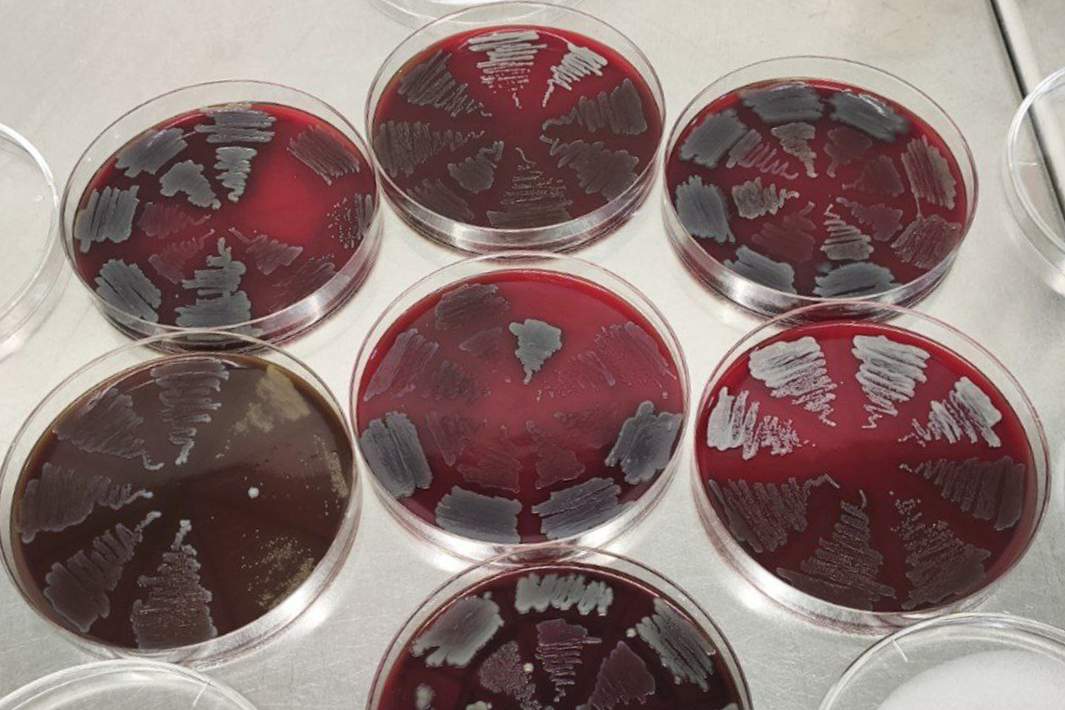
Бактерии
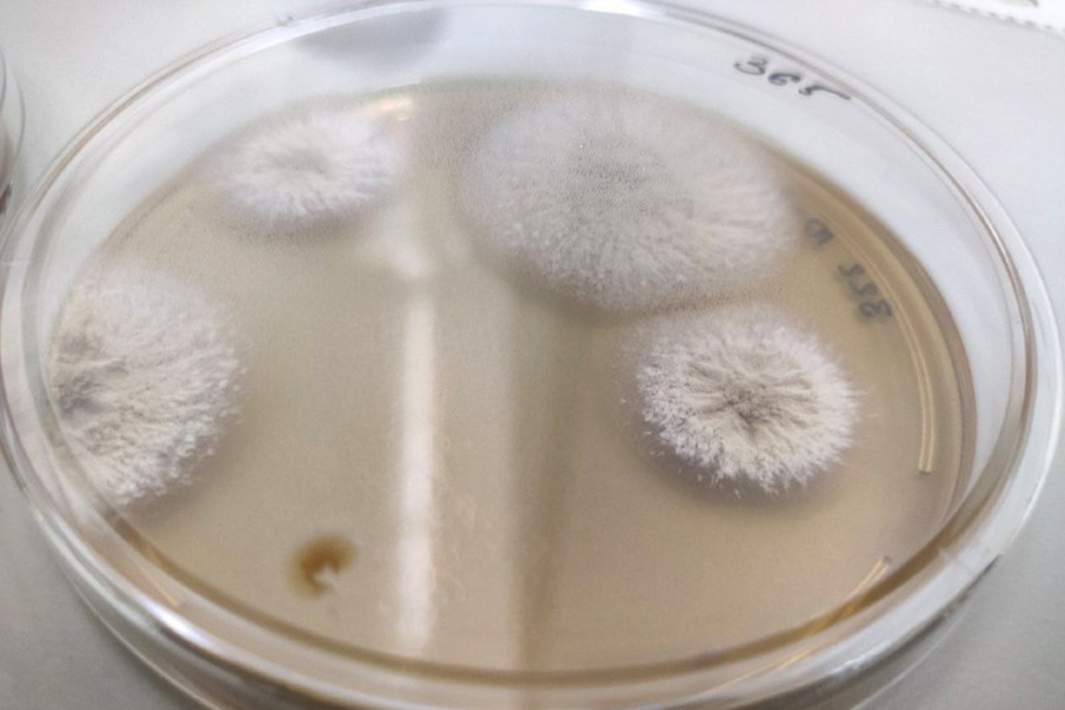
Гриб

- Статьи
- Science and technology
- Farm Secret: Probiotics will increase cow productivity and make meat safer
Farm Secret: Probiotics will increase cow productivity and make meat safer

Russian researchers have made an important discovery for agriculture, proving that the health and fertility of cows directly depend on their microflora. Scientists from St. Petersburg Agrarian University have shown that a probiotic supplement based on Bacillus sp. bacteria effectively fights pathogenic microorganisms that cause inflammation in animals and eliminates the use of antibiotics, which will make meat and milk safer. For more information, see the Izvestia article.
Reproductive health of cows
Scientists from St. Petersburg State Agrarian University (SPbGAU), specialists from Gatchinskoe and Biotrof+ companies have established how a probiotic feed additive based on Bacillus sp bacteria. (a genus of gram-positive rod-shaped bacteria) improves digestion and the composition of the microbiota of the rumen and intestines, and also affects the condition of the uterus of cows.
In the course of the study, ten cows from the experimental group were given a probiotic in their daily diet three weeks before and for three weeks after the calf was born. The control group, which also consisted of ten animals, received standard nutrition. In addition, the scientists took scrapings from the inner layer of the uterus from three cows from each group.
Using the polymerase chain reaction, which allows the DNA to determine the species of bacteria, scientists have found that the probiotic significantly reduces the number of pathogenic bacteria that cause inflammation in the reproductive system. Moreover, the animals from the experimental group were more quickly ready for the next fertilization. This proves that the use of probiotics can increase productivity and reduce the amount of antibiotics and other drugs, reducing the risk of their ingestion into human food.
— The results obtained indicate how important it is to monitor the state of the microbiota of the uterus of animals during pregnancy and milk production. Regular analyses and the use of dietary supplements can help to identify abnormalities in the condition of cows in a timely manner and take the necessary measures, which can significantly reduce the risk of complications," said Elena Yildirim, Doctor of Biological Sciences, Professor at St. Petersburg State University, project manager.
The health of cows, as well as their reproductive ability, depends on the composition of microorganisms in the digestive tract. However, recently, high-energy diets, characterized by a high sugar and starch content, have been used in agriculture to produce large volumes of milk. Such feeding negatively affects the microbiota of the rumen — the first part of the stomach — and intestines and stimulates the proliferation of pathogenic bacteria that contribute to the development of inflammation in the uterus and decreased fertility in cows.
According to scientists, cows become the most vulnerable three weeks before and three weeks after the birth of a calf. During this period, nutrients are first spent on the active growth of the embryo, and then on the production of milk. Improper nutrition can lead to serious diseases, including reproductive cycle disorders. Thus, adding microbiota-restoring feed additives that are safe for humans to the diet will potentially improve animal health.
Farms without antibiotics
In the future, the authors plan to use biologics aimed directly at the uterine microbiota. This approach will enhance the positive effect of probiotics and localize their effect in the most vulnerable place. The preparations will contain carefully selected cultures capable of restoring the natural balance of the microbiota, strengthening the protective properties of the mucous membrane and preventing the occurrence of inflammatory reactions, thereby creating favorable conditions for carrying the fetus and increasing productivity.
The microflora performs an important function to provide the animal body with a complete protein, the amino acid composition of which depends on the set of feeds in the diet, which underlines the importance of using additives in animal husbandry, the head of the Smart Supply Chain segment of the FoodNet working group told Izvestia NTI Sergey Kosogor. Moreover, probiotics can be used for disinfection of premises and manure treatment, and their use can significantly reduce the level of bacterial contamination on the farm.
— The development of scientists is of great importance, since the use of biologically active additives in addition to the basic diet of dairy cows increases the activity of metabolism, affects the structure of the intestinal mucosa, determines its colonization resistance, which also causes changes in the biochemical parameters of animal blood. In addition, probiotics inhibit the growth of pathogenic bacteria, increase immune protection, regulate intestinal pH, and reduce the cost of treating animals," the specialist noted.
He also stressed that the opportunity to abandon antibiotics in the production of beef and milk is also important.
Prebiotic additives in the diet of cows can really have a positive effect on the dairy productivity of animals, including the frequency of calving and milk quality, Regina Gurina, associate professor at the RUDN Agricultural Institute of Technology, told Izvestia.
— Prebiotics can help increase milk yields, improve the composition of milk (for example, by increasing the protein and fat content), as well as reduce the number of somatic cells, which indicates better breast health of the animal. However, the results may depend on the type of prebiotic, dosage and general condition of the livestock, so recommendations for use should be formed taking into account the specifics of the farm and under the supervision of a veterinarian," the specialist said.
The results of the study, supported by a grant from the Russian Science Foundation (RSF), are published in the journal Bulletin of the KrasGAU.
Переведено сервисом «Яндекс Переводчик»